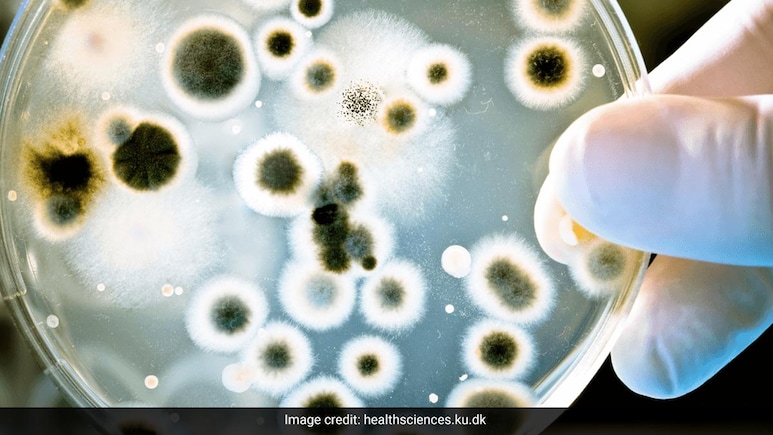
High Levels Of Antibiotic Resistant Superbugs In Delhi Air Posing Public Health Risks: Study

High levels of antibiotic-resistant superbugs in both indoor and outdoor environments in Delhi are posing public health risks, according to a study.
Airborne microbial contamination, especially involving antibiotic-resistant bacteria and antibiotic resistance genes, poses a growing public health concern in urban environments.
The study, by researchers at the Jawaharlal Nehru University, explored the prevalence and diversity of staphylococci, including methicillin-resistant staphylococci (MRS), in bioaerosols from various urban settings in Delhi, India.
Indoor and outdoor air samples showed significantly high staphylococcal loads far above the WHO's recommended limit for microbial exposure.
Seasonal variations revealed a peak in airborne MRS during winter, while monsoon rains reduced outdoor bioaerosol contamination.
The study assessed the prevalence and diversity of staphylococci in bioaerosols from various urban environments in Delhi, including Vasant Vihar Urban Slum (VVUS), Munirka Market Complex (MMC), Munirka Apartment (MA), and the Sewage Treatment Plant at Jawaharlal Nehru University (STP, JNU).
“Eight staphylococcal species were identified, with Staphylococcus epidermidis and Staphylococcus arlettae being the most prevalent human- and animal-associated species, respectively,” said the researchers Himani Kumari and Madhuri Singh, from JNU's School of Environmental Sciences, in the paper.
Notably, 73 per cent of MRS isolates exhibited multidrug resistance (MDR), showing resistance to macrolides, beta-lactams, and other commonly used antibiotics.
Genotypic analysis confirmed the presence of ARGs among airborne MRS encoding resistance for beta-lactam, trimethoprim, gentamicin, macrolides, chloramphenicol, and lincosamides.
Notably, 14 out of 36 MDR isolates carried the mecA gene encoding for methicillin resistance.
“This study emphasises the potential health risks posed by airborne reservoirs of antibiotic resistance in urban environments and underscores the urgent need for comprehensive environmental AMR surveillance to develop effective mitigation strategies,” the team said.
The study highlights the critical need for comprehensive monitoring and reporting on environmental AMR, including both antibiotic-resistant bacteria and their associated genetic markers.
“Such efforts are essential to accurately assess the scope of the AMR threat and to inform the development of integrated action plans aimed at mitigating the growing challenges posed by AMR in urban settings,” the researchers said.
(Except for the headline, this story has not been edited by NDTV staff and is published from a syndicated feed.)